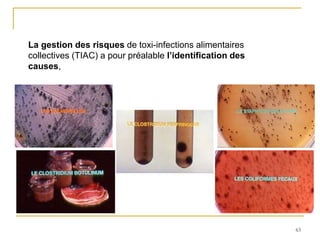
63
La gestion des risques de toxi-infections alimentaires
collectives (TIAC) a pour préalable l’identification des
causes,

Le document présente les règles essentielles d'hygiène en cuisine, qui comprennent l'hygiène personnelle, le respect des températures, le nettoyage et la désinfection, et le contrôle. Il insiste sur l'importance de la propreté et des procédures appropriées pour prévenir la contamination des aliments. Des inspections régulières et une formation continue du personnel sont nécessaires pour garantir le respect de ces pratiques d'hygiène.